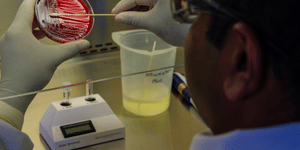
Expected NEET SS 2025 Cutoff Scores for ENT

The FMGE 2025 Exam is conducted for foreign medical graduates who aspire to practice medicine in India. The minimum score required for the FMGE 2025 Dec Session qualification is 150 out of 300. Therefore, candidates aspiring for the FMGE 2025 Dec session exam and securing a score of above 210 out of 300 will be considered a good score in the FMGE 2025 exam. The total marks for the FMGE 2025 exam are 300, and the minimum percentage required to pass the FMGE Exam 2025 is 50%. Students eager to know more about the Good Score in FMGE 2025 can go through the good scores in FMGE 2026 stats, what happens after the FMGE exam, etc.

The last 30 Days FMGE 2025 Preparation should mainly focus on taking mock tests and revising the high-yield topics. This is the time to strengthen your understanding of what you have already studied to ensure you have a firm grasp of all the key topics before the exam. Instead of focusing on learning any new material, stick to a set weekly schedule, revising major topics, and focusing on difficult topics.

NEET PG Round 3 Counselling Schedule 2025: The Medical Counselling Committee will soon release the NEET PG Round 3 counselling schedule. Already, the NEET PG Round 2 counselling registration had concluded on December 30, 2025, and now the candidates are waiting to complete the extended Round 2 counselling reporting process. For the latest updates regarding the MCC NEET PG Round 3 counselling dates, the candidates are advised to constantly check the official website- mcc.nic.in.

NEET UG 2026: The National Testing Agency (NTA) has released important instructions for NEET UG 2026 candidates, suggesting that they get their documents updated and verified well before the start of the registration process. According to the notification, candidates must ensure that their Aadhaar details, UDID (Unique Disability ID) for PwD candidates, and category certificates like SC, ST, OBC-NCL and EWS are correct, valid and not expired. In case of any discrepancy or when the information is not updated, it can cause problems while filling up the application form online, during the document verification process, counseling or at the time of seat allotment. Avoiding any last-minute hassles and disqualification of candidature, candidates are advised to get the corrections done beforehand and have the documents ready before the NEET UG 2026 application window opens.
NEET Super Specialty (NEET SS) exam is conducted by the National Board of Examinations in Medical Sciences (NBEMS) for DM, MCh, and DrNB courses at a national level. NEET SS 2025 exam have been conducted now and students looking for ENT admission must score more than the expected cutoffs to reserve their seat. NEET SS 2025 cutoffs depend on many factors such as exam difficulty, total test-takers, and availability of seats.
Kolkata (West Bengal)
Chennai (Tamil Nadu)
Salem (Tamil Nadu)
Bengaluru (Karnataka)
Tindivanam (Tamil Nadu)